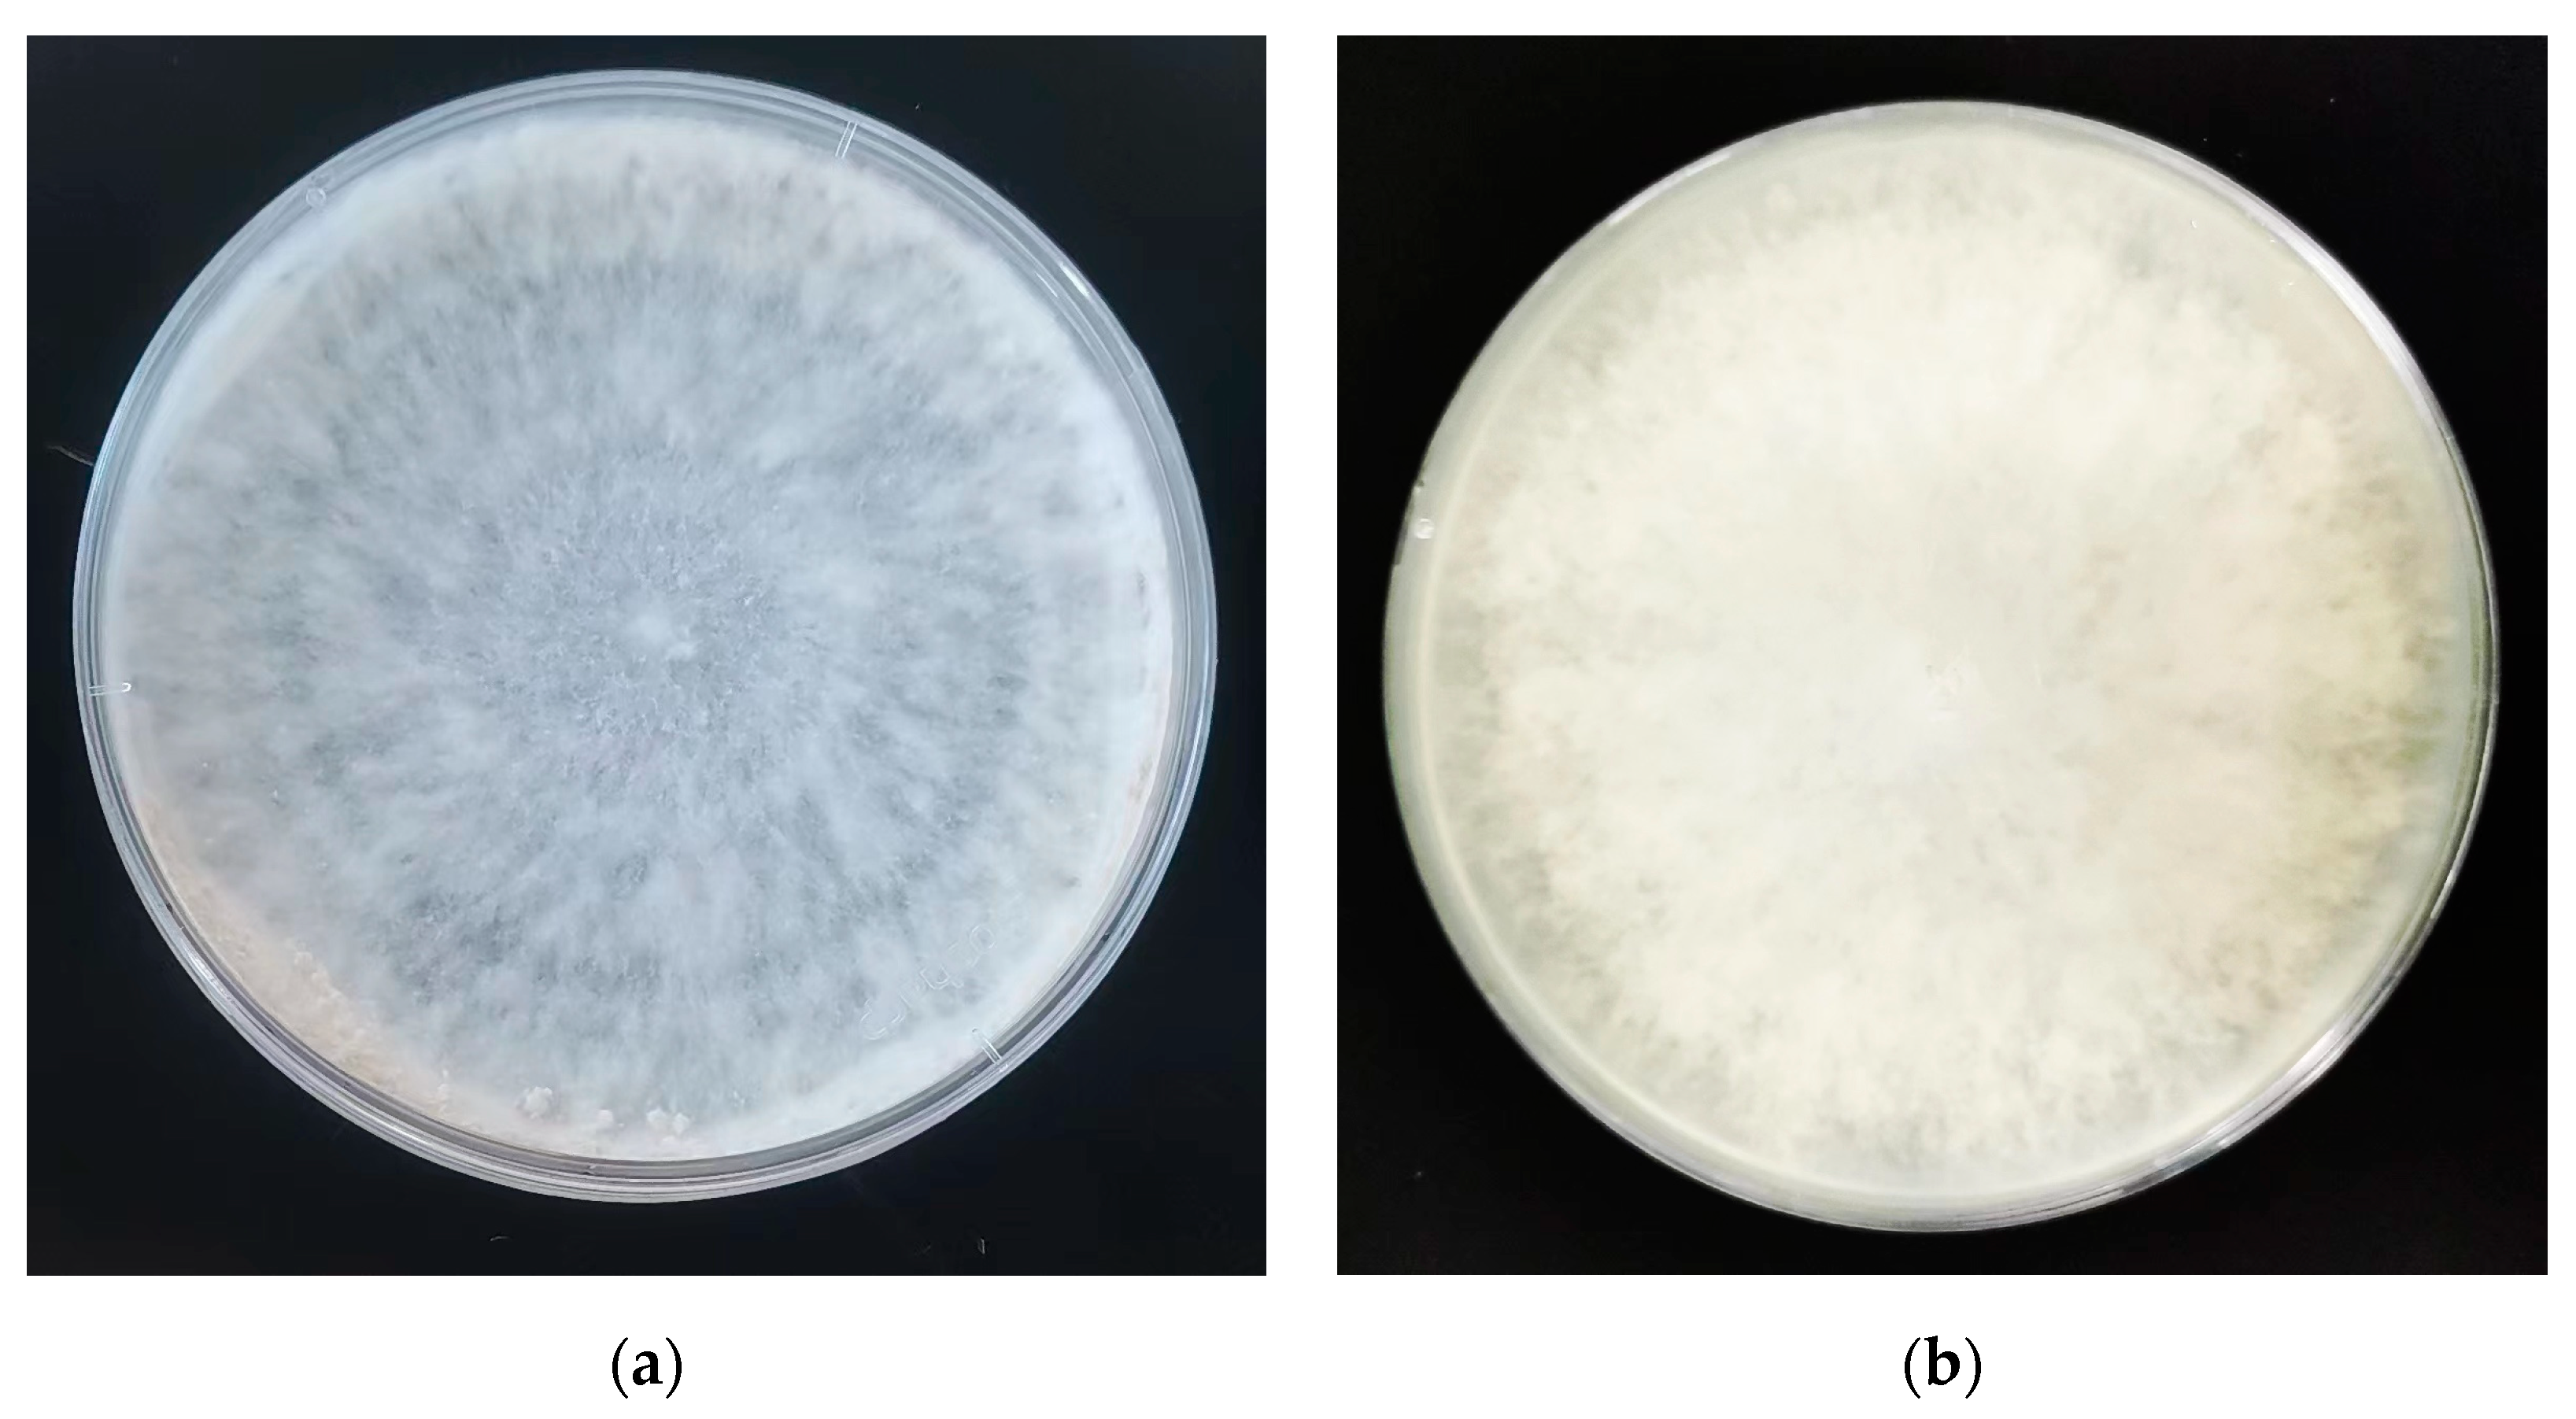
Forests 15 01673 g003

Identification of a Fomitopsis pinicola from Xiaoxing’an Mountains and Optimization of Cellulase Activity
Abstract
1. Introduction
2. Materials
3. Methods
3.1. Molecular Biological Identification
3.1.1. DNA Extraction
3.1.2. Phylogenetic Analysis
3.2. Identification of Morphology
3.3. Preparation of Glucose Standard Curves
3.4. Extraction of Crude Enzyme Solution
3.5. Determination of the Cellulase Activity
3.5.1. Determination of Endoglucanase (CMCase)
3.5.2. Determination of the β-Glucosidase Activity
3.6. Optimization of Cellulase Production Conditions
3.6.1. Optimal Initial Reaction pH
3.6.2. Different Carbon Sources
3.6.3. Different Nitrogen Source
3.6.4. Orthogonal Experimental Design
4. Results and Discussions
4.1. Molecular Biology Identification Results
4.2. Morphological Identification Results
4.3. Cellulase Production Optimization Results
4.3.1. The Initial pH on Cellulase Activity
4.3.2. Carbon Sources on Cellulase Activity
4.3.3. Nitrogen Sources on Cellulase Activity
4.3.4. Effect of Orthogonal Experimental Optimization on Cellulase Production by Fomitopsis pinicola
5. Conclusions
Author Contributions
Funding
Data Availability Statement
Conflicts of Interest
References
- Andres, B.; Krajewski, K.J.; Betlej, I. Diversity of indoor wood decaying fungi in poland. Bioresources 2022, 17, 4856–4869. [Google Scholar] [CrossRef]
- Witomski, P.; Olek, W.; Bonarski, J.T. Changes in strength of scots pine wood (Pinus silvestris L.) decayed by brown rot (coniophora puteana) and white rot (trametes versicolor). Constr. Build. Mater. 2016, 102, 162–166. [Google Scholar] [CrossRef]
- Li, X.; Wang, Y.; Yang, Z.; Liu, T.; Mu, C. Photosynthesis adaption in korean pine to gap size and position within populus davidiana forests in xiaoxing’anling, china. J. For. Res. 2022, 33, 1517–1527. [Google Scholar] [CrossRef]
- Fukasawa, Y. Ecological impacts of fungal wood decay types: A review of current knowledge and future research directions. Ecol. Res. 2021, 36, 910–931. [Google Scholar] [CrossRef]
- Goodell, B.; Winandy, J.E.; Morrell, J.J. Fungal degradation of wood: Emerging data, new insights and changing perceptions. Coatings 2020, 10, 1210. [Google Scholar] [CrossRef]
- Valle-Perez, A.U.; Flores-Cosio, G.; Amaya-Delgado, L. Bioconversion of agave bagasse to produce cellulases and xylanases by penicillium citrinum and aspergillus fumigatus in solid-state fermentation. Waste Biomass Valorization 2021, 12, 5885–5897. [Google Scholar] [CrossRef]
- Ariff, I.N.M.; Bahrin, E.K.; Ramli, N.; Abd-Aziz, S. Direct use of spent mushroom substrate from pleurotus pulmonarius as a readily delignified feedstock for cellulase production. Waste Biomass Valorization 2019, 10, 839–850. [Google Scholar] [CrossRef]
- Tsujiyama, S.; Okada, A. Biodegradation of polyvinyl alcohol by a brown-rot fungus, Fomitopsis pinicola. Biotechnol. Lett. 2013, 35, 1907–1911. [Google Scholar] [CrossRef]
- Singh, R.; Saati, A.A.; Faidah, H.; Bantun, F.; Jalal, N.A.; Haque, S.; Rai, A.K.; Srivastava, M. Prospects of microbial cellulase production using banana peels wastes for antimicrobial applications. Int. J. Food Microbiol. 2023, 388, 110069. [Google Scholar] [CrossRef]
- Espejo, F. Role of commercial enzymes in wine production: A critical review of recent research. J. Food Sci. Tech. 2021, 58, 9–21. [Google Scholar] [CrossRef]
- Kumar, J.A.; Kumar, M.S. A study on improving dyeability of polyester fabric using lipase enzyme. Autex Res. J. 2020, 20, 243–249. [Google Scholar] [CrossRef]
- Devi, A.; Jaryal, R.; Bhatia, C.; Singh, N. Elucidating the potential of cellulases isolated from a locally isolated strain (nsf-2) in paper and pulp industry. Clean. Mater. 2022, 6, 100139. [Google Scholar] [CrossRef]
- Sutaoney, P.; Rai, S.N.; Sinha, S.; Choudhary, R.; Gupta, A.K.; Singh, S.K.; Banerjee, P. Current perspective in research and industrial applications of microbial cellulases. Int. J. Biol. Macromol. 2024, 264, 130639. [Google Scholar] [CrossRef] [PubMed]
- Oses, R.; Valenzuela, S.; Freer, J.; Baeza, J.; Rodríguez, J. Evaluation of fungal endophytes for lignocellulolytic enzyme production and wood biodegradation. Int. Biodeterior. 2006, 57, 129–135. [Google Scholar] [CrossRef]
- Saravanan, P.; Muthuvelayudham, R.; Kannan, R.R.; Viruthagiri, T. Optimization of cellulase production using trichoderma reesei by rsm and comparison with genetic algorithm. Front. Chem. Sci. 2012, 6, 443–452. [Google Scholar] [CrossRef]
- Lin, Y.; He, X.; He, X.; Huang, Y.; Chen, Y. Optimization of enzyme-producing conditions and cellulases characteristics of a cellulose-decompsing endophyte. Gnkubw 2012, 39, 134–137. [Google Scholar]
- Adriana Sanchez-Quitian, Z.; Carlos Quitian-Romero, J.; Tatiana Moreno-Buitrago, A.; Montoya Barreto, S.; Sanjuan, T.; Ortiz-Rosas, J.P. Isolation and characterization of wood-decomposing basidiomycetes from the andean forest in boyaca, colombia. Braz. J. Microbiol. 2022, 53, 1425–1437. [Google Scholar] [CrossRef]
- Li, Y.; Zhang, P.; Zhu, D.; Yao, B.; Hasunuma, T.; Kondo, A.; Zhao, X. Efficient preparation of soluble inducer for cellulase production and saccharification of corn stover using in-house generated crude enzymes. Biochem. Eng. J. 2022, 178, 108296. [Google Scholar] [CrossRef]
- Ejaz, U.; Sohail, M.; Ghanemi, A. Cellulases: From bioactivity to a variety of industrial applications. Biomimetics 2021, 6, 44. [Google Scholar] [CrossRef]
- Zhang, L.; Xie, Q.; Yang, L.; Wu, Y.; Ma, X. Prediction model based on chemical composition change for the mechanical degradation of korean pine (pinus koraiensis) after brown-rot fungi (gloeophyllum trabeum) invasion. Holzforschung 2022, 76, 68–76. [Google Scholar] [CrossRef]
- Sugano, J.; Maina, N.; Wallenius, J.; Hilden, K. Enhanced lignocellulolytic enzyme activities on hardwood and softwood during interspecific interactions of white- and brown-rot fungi. J. Fungi 2021, 7, 265. [Google Scholar] [CrossRef] [PubMed]
- Costa, L.G.; Paes, J.B.; De Jesus-Junior, W.C.; Brocco, V.F.; Pinho, D.B. Isolation and identification of fungi with potential for biological stump removal of Eucalyptus spp. J. Trop. For. Sci. 2020, 32, 154–160. [Google Scholar] [CrossRef]
- Beeckmans, H.; Van Roy, E.; Kaes, J.; Sacreas, A.; Geudens, V.; Vermaut, A.; Willems, L.; Jin, X.; Bos, S.; Vanstapel, A.; et al. Aspergillus-specific igg antibodies are associated with fungal-related complications and chronic lung allograft dysfunction after lung transplantation. Transpl. Int. 2023, 36, 10768. [Google Scholar] [CrossRef] [PubMed]
- He, P.; Wang, H.; Yan, Y.; Zhu, G.; Chen, Z. Development and application of a multiplex fluorescent pcr for shigella detection and species identification. J. Fluoresc. 2022, 32, 707–713. [Google Scholar] [CrossRef] [PubMed]
- Biziks, V.; Bicke, S.; Koch, G.; Militz, H. Effect of phenol-formaldehyde (pf) resin oligomer size on the decay resistance of beech wood. Holzforschung 2021, 75, 574–583. [Google Scholar] [CrossRef]
- Khosravi, F.; Khaleghi, M.; Naghavi, H. Screening and identification of cellulose-degrading bacteria from soil and leaves at kerman province, iran. Arch. Microbiol. 2022, 204, 88. [Google Scholar] [CrossRef]
- Menezes, F.S.R.; da Cruz, G.G.; Lopes, M.D.O.; Nelson, D.L.; Martins, T.Q.G.; de Laia, M.L. Evaluation of endoglucanase and β-glucosidase production by bacteria and yeasts isolated from a eucalyptus plantation in the cerrado of minas gerais. Rev. Ambient. Agua 2019, 14, e2324. [Google Scholar] [CrossRef]
- Siva, D.; Srivethi, G.; Vasan, P.T.; Rajesh, D.; Alfarhan, A.; Rajagopal, R. Enhanced cellulase enzyme production by aspergillus niger using cellulase/iron oxide magnetic nano-composites. J. King Saud Univ. Sci. 2022, 34, 101695. [Google Scholar] [CrossRef]
- De Paula, C.C.P.; Montoya, Q.V.; Meirelles, L.A.; Farinas, C.S.; Rodrigues, A.; Seleghim, M.H.R. High cellulolytic activities in filamentous fungi isolated from an extreme oligotrophic subterranean environment (catao cave) in brazil. An. Acad. Bras. Cienc. 2019, 91, e20180583. [Google Scholar] [CrossRef]
- Fang, H.; Li, C.; Zhao, J.; Zhao, C. Biotechnological advances and trends in engineering trichoderma reesei towards cellulase hyperproducer. Biotechnol. Bioprocess Eng. 2021, 26, 517–528. [Google Scholar] [CrossRef]
- Pramanik, S.K.; Mahmud, S.; Paul, G.K.; Jabin, T.; Naher, K.; Uddin, M.S.; Zaman, S.; Saleh, M.A. Fermentation optimization of cellulase production from sugarcane bagasse by bacillus pseudomycoides and molecular modeling study of cellulase. Curr. Microbiol. 2021, 2, 100013. [Google Scholar] [CrossRef] [PubMed]
- Li, C.; Margenot, A.J. Apparent kinetic properties of soil phosphomonoesterase and beta-glucosidase are disparately influenced by ph. Soil Sci. Soc. Am. J. 2021, 85, 2007–2018. [Google Scholar] [CrossRef]
- Sulyman, A.O.; Igunnu, A.; Malomo, S.O. Isolation, purification and characterization of cellulase produced by aspergillus niger cultured on arachis hypogaea shells. Heliyon 2020, 6, e05668. [Google Scholar] [CrossRef] [PubMed]
- Khanjani, M.H.; Alizadeh, M.; Mohammadi, M.; Aliabad, S.H. Biofloc system applied to nile tilapia (oreochromis niloticus) farming using different carbon sources: Growth performance, carcass analysis, digestive and hepatic enzyme activity. Iran J. Fish. Sci. 2021, 20, 490–513. [Google Scholar]
- Srivastava, N.; Singh, R.; Srivastava, M.; Syed, A.; Pal, D.B.; Bahkali, A.H.; Mishra, P.K.; Gupta, V.K. Impact of mixed lignocellulosic substrate and fungal consortia to enhance cellulase production and its application in NiFe2O4 nanoparticles mediated enzymatic hydrolysis of wheat straw. Bioresour. Technol. 2022, 345, 126560. [Google Scholar] [CrossRef]
- Lee, E.-J.; Gao, W.; Lee, J.-W. Enhanced production of carboxymethylcellulase of bacillus subtilis subsp subtilis a-53 by a recombinant escherichia coli jm109/a-53 with ph and temperature shifts. Korean J. Chem. Eng. 2015, 32, 113–117. [Google Scholar] [CrossRef]
- Singhania, R.R.; Sukumaran, R.K.; Patel, A.K.; Larroche, C.; Pandey, A. Advancement and comparative profiles in the production technologies using solid-state and submerged fermentation for microbial cellulases. Enzym. Microb. Tech. 2010, 46, 541–549. [Google Scholar] [CrossRef]
- Csarman, F.; Obermann, T.; Zanjko, M.C.; Man, P.; Halada, P.; Seiboth, B.; Ludwig, R. Functional expression and characterization of two laccases from the brown rot fomitopsis pinicola. Enzym. Microb. Tech. 2021, 148, 109801. [Google Scholar] [CrossRef] [PubMed]
- Marques, N.P.; de Cassia Pereira, J.; Gomes, E.; da Silva, R.; Araújo, A.R.; Ferreira, H.; Rodrigues, A.; Dussán, K.J.; Bocchini, D.A. Cellulases and xylanases production by endophytic fungi by solid state fermentation using lignocellulosic substrates and enzymatic saccharification of pretreated sugarcane bagasse. Ind. Crops. Prod. 2018, 122, 66–75. [Google Scholar] [CrossRef]
- Deswal, D.; Khasa, Y.P.; Kuhad, R.C. Optimization of cellulase production by a brown rot fungus fomitopsis sp. Rck2010 under solid state fermentation. Bioresour. Technol. 2011, 102, 6065–6072. [Google Scholar] [CrossRef]
- Xie, H.; Wu, B.; Liu, G.; Li, X. Optimization of in situ cellulase production from penicillium oxalicum p-07 under submerged fermentation conditions with different cellulose types. J. Environ. Chem. Eng. 2023, 11, 110290. [Google Scholar] [CrossRef]
- Kathirgamanathan, M.; Weerasinghe, S.; Bowange, T.K.; Abayasekara, C.L.; Kulasooriya, S.A.; Ratnayake, R.R. Evaluation of co-culture of cellulolytic fungi for enhanced cellulase and xylanase activity and saccharification of untreated lignocellulosic material. Folia Microbiol. 2024. [CrossRef] [PubMed]
- Chakraborty, S.; Gupta, R.; Jain, K.K.; Kuhad, R.C. Cost-effective production of cellulose hydrolysing enzymes from trichoderma sp rck65 under ssf and its evaluation in saccharification of cellulosic substrates. Biotechnol. Bioprocess Eng. 2016, 39, 1659–1670. [Google Scholar] [CrossRef] [PubMed]

| Levels | Factors | |||
|---|---|---|---|---|
| A//g/L | B//g/L | C//mL | D//pcs | |
| 1 | 5 | 5 | 60 | 2 |
| 2 | 10 | 10 | 80 | 4 |
| 3 | 15 | 15 | 100 | 6 |
| No. | A | B | C | D | U/mL |
|---|---|---|---|---|---|
| 1 | 1 | 1 | 1 | 1 | 20.94 |
| 2 | 1 | 2 | 2 | 2 | 80.73 |
| 3 | 1 | 3 | 3 | 3 | 31.86 |
| 4 | 2 | 1 | 2 | 3 | 19.65 |
| 5 | 2 | 2 | 3 | 1 | 81.17 |
| 6 | 2 | 3 | 1 | 2 | 105.89 |
| 7 | 3 | 1 | 3 | 2 | 26.63 |
| 8 | 3 | 2 | 1 | 3 | 30.56 |
| 9 | 3 | 3 | 2 | 1 | 116.94 |
| K1 | 44.51 | 22.41 | 52.46 | 73.19 | |
| K2 | 68.9 | 64.15 | 72.44 | 71.08 | |
| K3 | 85.46 | 84.89 | 46.55 | 27.35 | |
| R | 40.95 | 62.48 | 25.89 | 43.59 |
Disclaimer/Publisher’s Note: The statements, opinions and data contained in all publications are solely those of the individual author(s) and contributor(s) and not of MDPI and/or the editor(s). MDPI and/or the editor(s) disclaim responsibility for any injury to people or property resulting from any ideas, methods, instructions or products referred to in the content. |
© 2024 by the authors. Licensee MDPI, Basel, Switzerland. This article is an open access article distributed under the terms and conditions of the Creative Commons Attribution (CC BY) license (https://creativecommons.org/licenses/by/4.0/).
Share and Cite
Sun, J.; Yang, H.; Ge-Zhang, S.; Chi, Y.; Qi, D. Identification of a Fomitopsis pinicola from Xiaoxing’an Mountains and Optimization of Cellulase Activity. Forests 2024, 15, 1673. https://doi.org/10.3390/f15091673
Sun J, Yang H, Ge-Zhang S, Chi Y, Qi D. Identification of a Fomitopsis pinicola from Xiaoxing’an Mountains and Optimization of Cellulase Activity. Forests. 2024; 15(9):1673. https://doi.org/10.3390/f15091673
Chicago/Turabian StyleSun, Jing, Hong Yang, Shangjie Ge-Zhang, Yujie Chi, and Dawei Qi. 2024. "Identification of a Fomitopsis pinicola from Xiaoxing’an Mountains and Optimization of Cellulase Activity" Forests 15, no. 9: 1673. https://doi.org/10.3390/f15091673
APA StyleSun, J., Yang, H., Ge-Zhang, S., Chi, Y., & Qi, D. (2024). Identification of a Fomitopsis pinicola from Xiaoxing’an Mountains and Optimization of Cellulase Activity. Forests, 15(9), 1673. https://doi.org/10.3390/f15091673






